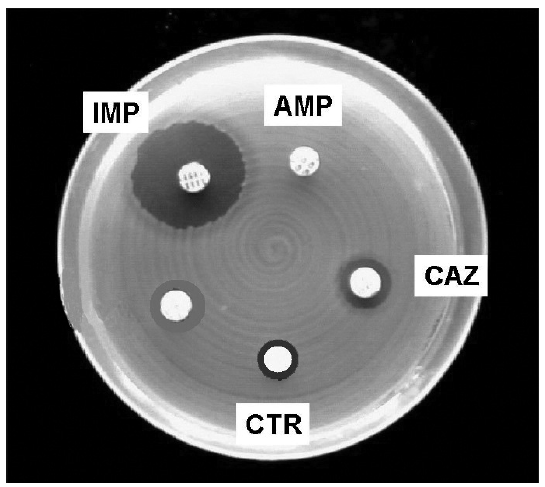

Biologija - 2017./18. ljeto - 47.
47. Na slici su prikazani rezultati antibiograma. Kratice na slici označavaju diskove s različitim antibioticima koji su u istim dozama postavljeni na hranidbenu podlogu s uzgojenim bakterijama istoga soja.
Kojom je kraticom označen najučinkovitiji antibiotik?